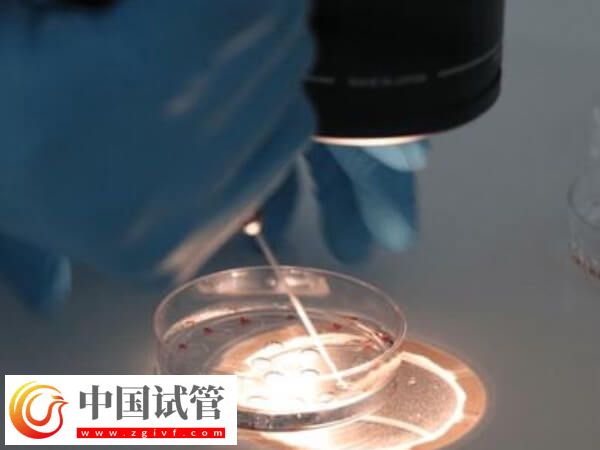
嵌合體30%其實也可以做試管嬰兒移植，比例才是成功關鍵(圖1)

日韩激情在线观看_狠狠网亚洲精品_成人高清在线视频_麻豆精品国产传媒mv男同_不卡电影一区二区三区_美女性感视频久久_91性感美女视频_久久成人免费电影_99亚偷拍自图区亚洲_视频一区中文字幕国产
国产sm精品调教视频网站|
蜜臀av亚洲一区中文字幕|
水野朝阳av一区二区三区|
免费在线观看一区二区三区|
国产一区二区日韩精品|
91在线观看一区二区|
精品一区二区三区在线视频|
成人黄页毛片网站|
韩国成人在线视频|
日韩激情一二三区|
成人av在线资源网|
激情深爱一区二区|
青青草一区二区三区|
不卡视频一二三四|
国产一区二区三区黄视频|
日本系列欧美系列|
91在线国产观看|
高清成人免费视频|
国内精品伊人久久久久av一坑|
91网站黄www|
国产高清一区日本|
精品亚洲aⅴ乱码一区二区三区|
91在线丨porny丨国产|
国v精品久久久网|
国产美女视频91|
久久www免费人成看片高清|
日韩国产精品久久|
日韩av不卡一区二区|
av男人天堂一区|
国产成人8x视频一区二区|
韩国欧美国产1区|
久久er精品视频|
精品系列免费在线观看|
狠狠色丁香久久婷婷综|
精品亚洲porn|
国产一区二区三区蝌蚪|
国产麻豆视频一区二区|
国产乱码精品1区2区3区|
国产精品一色哟哟哟|
国产乱码精品一区二区三区av|
国产综合久久久久久久久久久久|
蜜臀久久99精品久久久久宅男
|
成人在线综合网|
国产一区二区三区不卡在线观看|
乱一区二区av|
国内精品伊人久久久久av一坑|
久久爱另类一区二区小说|
美女一区二区视频|
精品制服美女丁香|
国产成人自拍高清视频在线免费播放|
国产精品18久久久久|
国产精品亚洲第一|
成人午夜伦理影院|
视频一区在线播放|
精品一区二区日韩|
夫妻av一区二区|
天堂影院一区二区|
久久99精品久久久久久|
国产成+人+日韩+欧美+亚洲|
99久久99久久久精品齐齐|
免费一级欧美片在线观看|
国产一二精品视频|
99久久精品国产导航|
免费在线观看成人|
大桥未久av一区二区三区中文|
97久久精品人人做人人爽50路|
日韩av网站在线观看|
国产一区二区三区精品欧美日韩一区二区三区
|
国产成人午夜精品5599|
91在线视频网址|
久久99久久精品欧美|
国产不卡视频一区|
免费的成人av|
成人精品免费视频|
激情综合五月婷婷|
爽爽淫人综合网网站|
国内成人自拍视频|
日日夜夜一区二区|
国产91精品一区二区麻豆亚洲|
91麻豆福利精品推荐|
91小视频在线|
精品一区二区在线视频|
99r国产精品|
国内成人自拍视频|
视频一区欧美日韩|
国产精品自拍在线|
捆绑变态av一区二区三区|
成人av网站在线观看|
精品亚洲免费视频|
天堂一区二区在线免费观看|
国产成人综合在线观看|
久久国产福利国产秒拍|
日产欧产美韩系列久久99|
成人激情校园春色|
国产精品一卡二卡|
激情欧美一区二区|
久久精品久久精品|
日韩精品久久理论片|
波多野结衣中文一区|
国产精品自在在线|
黄网站免费久久|
另类小说一区二区三区|
日本aⅴ精品一区二区三区|
99精品久久久久久|
www.亚洲在线|
成人免费观看av|
国产盗摄一区二区三区|
国产麻豆精品一区二区|
黄色资源网久久资源365|
麻豆精品在线观看|
久久精品久久99精品久久|
日本视频一区二区|
青青草视频一区|
蜜臀久久99精品久久久久宅男
|
奇米一区二区三区av|
99在线热播精品免费|
成人激情小说网站|
成人av网址在线观看|
av一区二区三区在线|
99国产精品久|
奇米888四色在线精品|
日韩精品色哟哟|
日韩影院免费视频|
美女视频网站黄色亚洲|
麻豆高清免费国产一区|
93久久精品日日躁夜夜躁欧美|
成人动漫在线一区|
天堂资源在线中文精品
|
风间由美一区二区三区在线观看|
国产一区二区视频在线|
国产精品一区二区你懂的|
粉嫩av一区二区三区|
成人激情文学综合网|
www.色精品|
天堂av在线一区|
久久99九九99精品|
高清国产一区二区|
99久久99精品久久久久久
|
蜜桃视频在线观看一区|
麻豆精品国产传媒mv男同|
狠狠色丁香婷综合久久|
国产不卡在线播放|
日韩中文欧美在线|
精油按摩中文字幕久久|
国产a久久麻豆|
日韩中文字幕一区二区三区|
国产在线播放一区二区三区|
成人黄色av网站在线|
秋霞国产午夜精品免费视频|
国产在线精品一区二区不卡了|
丰满白嫩尤物一区二区|
奇米影视一区二区三区|
国产成人精品亚洲日本在线桃色|
视频在线观看国产精品|
国产一区久久久|
91在线丨porny丨国产|
国精品**一区二区三区在线蜜桃|
成人激情av网|
精品无人区卡一卡二卡三乱码免费卡|
国产成人精品aa毛片|
日本欧美在线观看|
成人福利视频在线看|
91尤物视频在线观看|
国产91精品一区二区麻豆亚洲|
91麻豆免费视频|
国产老肥熟一区二区三区|
91麻豆高清视频|
国产成人综合自拍|
久久精品国产在热久久|
91小视频在线免费看|
95精品视频在线|
国产成人8x视频一区二区
|
国产一区二区三区不卡在线观看|
99精品国产91久久久久久
|
proumb性欧美在线观看|
精品一区二区三区久久|
丝袜a∨在线一区二区三区不卡|
国产一区二区三区不卡在线观看|
日韩av一二三|
成人激情午夜影院|
国产精品一区一区|
狠狠色伊人亚洲综合成人|
日韩中文欧美在线|
天堂成人免费av电影一区|
不卡高清视频专区|
国产成人精品影视|
国产精品69毛片高清亚洲|
久久精品99国产国产精|
日韩成人免费电影|
日韩专区在线视频|
首页欧美精品中文字幕|
99re这里只有精品6|
成人av午夜影院|
成人精品一区二区三区四区
|
国产剧情一区二区|
捆绑紧缚一区二区三区视频|
日本欧美久久久久免费播放网|
91网页版在线|
三级欧美在线一区|
日韩av电影免费观看高清完整版|
91麻豆国产福利精品|
视频一区二区三区在线|
日韩不卡一区二区三区|
日韩成人精品在线|
蜜臀av亚洲一区中文字幕|
捆绑调教一区二区三区|
激情久久五月天|
国产大陆a不卡|
成人动漫视频在线|
91视视频在线观看入口直接观看www
|
国产福利一区在线观看|
成人综合婷婷国产精品久久|
久久99久久精品|
国产在线精品不卡|
国产福利一区二区三区|
成人免费高清在线|
91丝袜呻吟高潮美腿白嫩在线观看|
91美女片黄在线观看|
欧美aaaaa成人免费观看视频|
美女mm1313爽爽久久久蜜臀|
国产一区欧美日韩|
av色综合久久天堂av综合|
日本中文一区二区三区|
极品美女销魂一区二区三区免费|
九一久久久久久|
国产.精品.日韩.另类.中文.在线.播放|
成人免费视频视频|
日本中文字幕一区|
国产精品白丝jk黑袜喷水|
成人av综合一区|
奇米影视在线99精品|
国产麻豆精品一区二区|
97久久超碰国产精品|
久久成人免费网站|
www.亚洲在线|
激情五月婷婷综合|
99精品视频在线观看|
久久99精品久久久久婷婷|
丁香一区二区三区|
美女视频一区在线观看|
成人免费av网站|
老汉av免费一区二区三区|
国产成人精品一区二|
日本在线观看不卡视频|
成人午夜精品在线|
九九国产精品视频|
91美女片黄在线观看|
国产一区999|
青青青爽久久午夜综合久久午夜|
国产suv精品一区二区883|
蜜臀久久99精品久久久画质超高清
|
美国一区二区三区在线播放
|
91看片淫黄大片一级|
国产成人日日夜夜|
精品夜夜嗨av一区二区三区|
av中文字幕不卡|
国产成人自拍网|
精东粉嫩av免费一区二区三区|
91视频精品在这里|
k8久久久一区二区三区|
国产精品一级黄|
日本aⅴ精品一区二区三区
|
看电视剧不卡顿的网站|
99久久精品一区|
国产69精品久久99不卡|
韩国欧美国产1区|
美女看a上一区|
日韩—二三区免费观看av|
99久久99久久精品免费看蜜桃|
国产高清不卡一区二区|
国产一区二区三区在线观看免费视频|
日韩av在线免费观看不卡|
91在线精品一区二区三区|
成人黄色小视频在线观看|
国产福利一区二区三区视频在线
|
99这里只有精品|
www.色精品|
波波电影院一区二区三区|
成人综合在线视频|
成人黄色国产精品网站大全在线免费观看|
国产乱码精品一区二区三区五月婷|
老司机精品视频在线|
麻豆精品一区二区三区|
美女视频黄a大片欧美|
男人的天堂久久精品|
男男成人高潮片免费网站|
免费看欧美美女黄的网站|
青草国产精品久久久久久|
秋霞午夜鲁丝一区二区老狼|
免费av成人在线|
精品亚洲成a人|
国产另类ts人妖一区二区|
国产成人一级电影|
成人动漫一区二区|
91亚洲男人天堂|
免费一区二区视频|
久99久精品视频免费观看|
国产乱妇无码大片在线观看|
粉嫩高潮美女一区二区三区|
97精品国产露脸对白|
日本系列欧美系列|
国精品**一区二区三区在线蜜桃|
国产一区二区三区免费播放|
国产成人精品一区二区三区网站观看
|
国产精品一二二区|
成人ar影院免费观看视频|
91免费观看视频|
久久精品国产一区二区三
|
成人av电影免费观看|
日韩在线观看一区二区|
久久国产欧美日韩精品|
美女久久久精品|
国产一区二区精品在线观看|
成人福利在线看|
美女免费视频一区二区|
国产大片一区二区|
99精品一区二区三区|
麻豆成人免费电影|
成人一区在线看|
日本亚洲免费观看|
国产精品自拍毛片|
日日夜夜一区二区|
国产福利一区二区三区视频|
日韩影院精彩在线|
国产一区二区按摩在线观看|
www.日韩大片|
韩国v欧美v日本v亚洲v|
av在线播放不卡|
国产麻豆日韩欧美久久|
日韩国产精品大片|
国产成人在线网站|
久久成人免费电影|
99久久精品国产毛片|
国产一区二区三区四区五区入口|
91一区一区三区|
国产成人精品免费网站|
免费观看在线色综合|
www.99精品|
国产精品69久久久久水密桃|
奇米影视一区二区三区|
av成人免费在线观看|
国产精品自拍三区|
久久99精品久久久久|
天堂一区二区在线免费观看|
国产精品一区二区三区四区|
琪琪一区二区三区|
97精品国产97久久久久久久久久久久|
国产一区二区三区四区五区美女
|
日韩精品一级中文字幕精品视频免费观看|
韩国精品一区二区|
免费观看日韩av|
丝袜亚洲另类丝袜在线|
成人动漫一区二区三区|
国产高清久久久|
国产一区二区三区美女|
久久精品久久99精品久久|
日日夜夜免费精品|
99久久久免费精品国产一区二区|
国产成人在线色|
国产馆精品极品|
国产精品99久久久久久有的能看|
久久精品99国产国产精|
蜜臀久久久99精品久久久久久|
天堂资源在线中文精品
|
捆绑紧缚一区二区三区视频|
91免费在线播放|
99re热这里只有精品视频|
国产一区不卡视频|
另类小说一区二区三区|
蜜桃视频在线观看一区|
免费精品视频最新在线|
美女视频网站久久|
久久精品国产99|
精品亚洲aⅴ乱码一区二区三区|
美女视频黄久久|
久久99久久99精品免视看婷婷|
久久91精品久久久久久秒播|
毛片不卡一区二区|
黄页网站大全一区二区|
国产电影一区在线|
成人激情午夜影院|
99免费精品视频|
日韩国产欧美三级|
麻豆成人久久精品二区三区小说|
久久精品噜噜噜成人av农村|
精品在线观看免费|
国产毛片一区二区|
丁香婷婷综合五月|
99精品视频一区|
欧美aaaaa成人免费观看视频|
久久成人久久鬼色|
国产福利一区在线|
k8久久久一区二区三区
|
北条麻妃国产九九精品视频|
91免费视频观看|
久久99久久99精品免视看婷婷|
国产一区视频网站|
成人三级伦理片|
琪琪一区二区三区|
国产一区不卡视频|